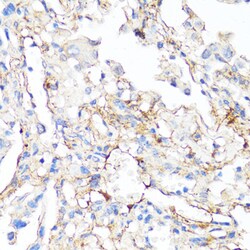

Promotional price valid on web orders only. Your contract pricing may differ. Interested in signing up for a dedicated account number?
Learn More
Learn More
Invitrogen™ Fibronectin Polyclonal Antibody


Rabbit Polyclonal Antibody
Supplier: Invitrogen™ PA5120475
This item is not returnable.
View return policy
Description
Positive test controls include: U-87MG, NIH/3T3. The target is usually found in the following locations: Secreted, extracellular matrix, extracellular space.
Fibronectin is a disulfide-bonded dimer with a molecular weight range of 230-250 kDa. In the extracellular matrix of several connective tissues and vessels, fibronectin is present as an insoluble protein that is extensively cross-linked by interchain disulfide bonds forming high molecular mass polymers. Fibronectin is most abundant during embryonic development and tissue remodeling. Fibronectin is also present at high concentrations as a soluble plasma protein. Fibronectin is organized as a linear series of repeating modules which form domains for interaction with fibronectin itself, other matrix components (e.g. collagen and heparin) and receptors on cells (e.g. integrins). Fibronectin is present in a soluble dimeric form in plasma, and in a dimeric or multimeric form at the cell surface and in extracellular matrix. Fibronectin is involved in cell adhesion and migration processes including embryogenesis, wound healing, blood coagulation, host defense, and metastasis. Fibronectin has been implicated in carcinoma development in lung cancer. Further, Fibronectin expression is increased especially in non-small cell lung carcinoma. The adhesion of lung carcinoma cells to Fibronectin enhances tumorgenecity and confers resistance to apoptosis induced by standard chemotherapeutic agents. The gene encoding Fibronectin has three regions subject to alternative splicing, with the potential to produce 20 different transcript variants. However, the full-length nature of some Fibronectin variants has not been determined.
Specifications
| Fibronectin | |
| Polyclonal | |
| Unconjugated | |
| FN1 | |
| Anastellin; CIG; Cold insoluble globulin (CIG); Cold-insoluble globulin; cumulus cell-specific fibronectin 1 transcript; DKFZp686F10164; DKFZp686H0342; DKFZp686I1370; DKFZp686O13149; E330027I09; ED-B; embryo-specific fibronectin 1 transcript; ferritin L subunit; ferritin L-chain; FIBNEC; fibronectin; fibronectin 1; fibronectin ED-A- region; fibronectin ED-B+ region; fibronectin variable region; FINC; FN; FN1; fn-1; FNZ; GFND; GFND2; LETS; LOW QUALITY PROTEIN: fibronectin; Migration stimulating factor (MSF); migration-stimulating factor; MSF; Ugl-Y1; Ugl-Y2; Ugl-Y3 | |
| Rabbit | |
| Affinity chromatography | |
| RUO | |
| 14268, 2335, 25661 | |
| -20°C, Avoid Freeze/Thaw Cycles | |
| Liquid |
| ELISA, Immunohistochemistry (Paraffin), Western Blot, Immunocytochemistry | |
| 0.26 mg/mL | |
| PBS with 50% glycerol and 0.09% sodium azide; pH 7.3 | |
| P02751, P04937, P11276 | |
| FN1 | |
| Recombinant protein (or fragment). | |
| 100 μL | |
| Primary | |
| Human, Mouse, Rat | |
| Antibody | |
| IgG |
Product Content Correction
Your input is important to us. Please complete this form to provide feedback related to the content on this product.
Product Title
Spot an opportunity for improvement?Share a Content Correction